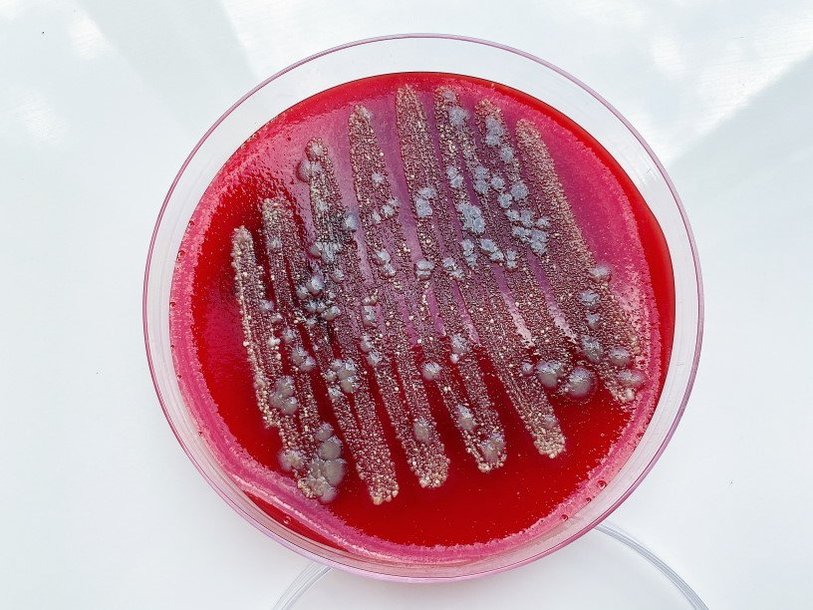

Екатерина Беленко: Промикробы: Бич Божий
Фото: Екатерина Беленко
Фото: Екатерина Беленко Считается, что уже в Ветхом Завете упоминается гонорея и некоторые наипростейшие методы её профилактики. Конечно, библейский текст можно трактовать по-разному, но то, что гонорея вместе с человеком давно и надолго — факт. Болезнь была знакома людям на протяжении многих веков, а вот с возбудителем первым познакомился немецкий врач Альберт Нейссер. В 1879 г. он не только обнаружил и назвал возбудителя этой болезни, но и описал его морфологические признаки, способы размножения бактерий и их действие на организм. В честь Нейссера полное латинское название гонококка звучит как Neisseria gonorrhoeae.
⠀
Гонококк — неподвижный грамотрицательный диплококк, то есть он представляет собой парную бактерию, внешне напоминающую кофейные зерна, сложенные вогнутыми сторонами внутрь. Гонококк имеет нежную капсулу и пили. Основной путь заражения — половой. Шанс заразиться гонореей даже после одного полового контакта с инфицированным партнером достигает 60–90 %. Рискованными являются все разновидности половых контактов, просто будет меняться зона поражения — половые органы, прямая кишка или горло. Возбудитель в том числе может передаваться через различные игрушки. Одни источники утверждают, что возможно заражение через такие предметы обихода, как мочалки, полотенца и белье, другие же отрицают такую возможность. В любом случае лучше носить свои трусы и вытираться своим полотенцем, согласны? Ребёнок заражается от матери в момент родов, когда проходит через инфицированные родовые пути.
⠀
Не все заразившиеся имеют проявления заболевания, бессимптомное течение чаще встречается у женщин. Симптомы могут появиться через пару-тройку дней, а могут и через пару-тройку недель. Это гнойные желто-зеленые выделения, боль, жжение и неприятные ощущения при мочеиспускании. Если не лечиться, то гонококк может пуститься в путь по организму, вызывая различные осложнения. У женщин он может забраться в матку, а оттуда через маточные трубы попасть в брюшную полость. Там маленький паршивец может приводить к внутренним абсцессам, хронической тазовой боли, бесплодию и внематочным беременностям. У мужчин гонококк распространяется до придатков яичек и, кроме боли, может привести и к бесплодию. А ещё гонококк хоть и редко, но может попасть в кровь, вызвать поражение суставов, сердца, мозга, кожи, независимо от пола жертвы. К сожалению, даже после успешного лечения возможно повторное заражение гонореей, поскольку не развивается стойкий иммунитет к этому микроорганизму.
⠀
Диагностировать гонорею можно по-разному: можно мазки изучать через микроскоп, можно на чашках Петри посев делать, можно методом ПЦР искать. У гонококков есть характерная особенность — их не напугать фагоцитозом. Они умудряются не только выживать, но и даже размножаться внутри нейтрофилов, прикиньте! Поэтому при микроскопии в мазках и в гнойном отделяемом они очень характерно расположены — не только снаружи, но и внутри фагоцитировавших их лейкоцитов.
⠀
Хоть человечество давно знакомо с гонореей, эффективного лечения не существовало до ХХ века, когда Александр Флеминг уехал в отпуск, не убрав перед этим своё рабочее место. Пенициллин оказался спасительным средством, лечение гонореи стало простым и доступным, но, как вы понимаете, появилось какое-то «но». Гонококк приобрёл устойчивость к пенициллину, его применение стало неэффективным. Затем история повторялась ещё несколько раз: находят работающий антибиотик, радостно лечат, он перестаёт работать, всё плохо. В 2018 году в Британии зафиксирован штамм гонореи, устойчивый ко всем видам антибиотиков. Есть сообщения о таких же случаях в Японии, Франции и Испании. Врачи опасаются начала эпидемии неизлечимой гонореи. Зато маски не надо будет носить.
Смотрите также: Екатерина Беленко Промикробы: Антикиллер Екатерина Беленко Промикробы: Инфекция наносит ответный удар Екатерина Беленко Промикробы: Красная и синяя таблетки Екатерина Беленко Промикробы: Плесень и липовый мёд